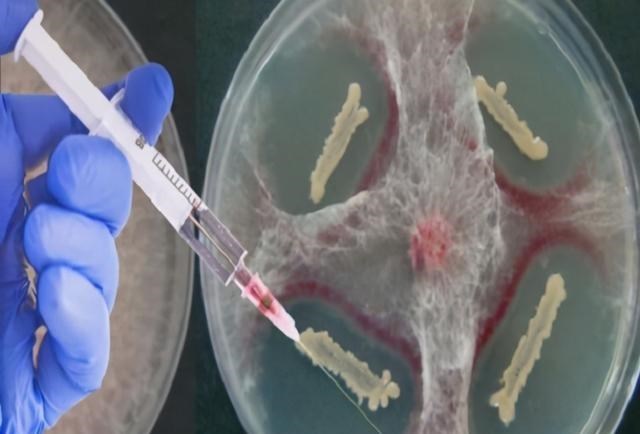
科学家 俄罗斯科学家为永生，注射350万年前的猛犸象细菌，后来怎样了？

文章图片
文章图片

文章图片

文章图片

文章图片
中国的哲学讲究的是天地万物 , 皆有定数 。 一切最终都会化为没有生命的尘土 , 只是时间的长短 。 正常人的一生寿命在70-90年 , 有些微生物可以活几百年 , 细菌的存活能力更强一些 , 可以活到上万年 , 长生不老一直是人们永恒追求的主题 。
当今社会处于极度发达的时代 , 致力于长生不老的科学家不在少数 。 但科学界普遍认为 , 可以通过科学手段 , 让人的寿命增加 , 但永远也不可能达到长生不老 , 因为宇宙的规律是无法违背的 。 就像科学家致力数百年 , 也无法研究出永动机一样 。 但还是有些科学家在长生不老的领域里 , 不断探究 。
一、意外发现神秘细菌
【科学家|俄罗斯科学家为永生,注射350万年前的猛犸象细菌,后来怎样了?】随着全球变暖 , 北极和西伯利亚地区冰川融化 , 冻土层出现在人们眼中 。 2009年在西伯利亚冻土层 , 科学家们发现了一具猛犸象尸体 。 猛犸象是远古时代的动物 , 距今1万年之前 , 猛犸象就陆续灭绝了。
莫斯科国立大学的科学家阿纳托利布·布鲁什科夫 , 是专门研究地球科学的 , 他将猛犸象带回实验室 。
在猛犸象尸体里 , 他发现了一种来自350万年前的细菌 , 布鲁什科夫给这种细菌取名叫 “芽孢杆菌F” 。 这种细菌有超强的休眠能力 , 能在缺氧、低温和黑暗环境中休眠 , 等到温度上升后再度苏醒 , 类似动物冬眠的原理 。 他还发现这个细菌对热量、酸碱度和辐射都有很高的耐性 。
但科学家们普遍认为 , 世界上不存在不会死亡的细菌 , 但有些细菌能自我修复 。 比如这个“芽孢杆菌F” , 它能在不断自我修复中 , 能持续地保持生命 。
二、硬核科学家以身实验
布鲁什科夫认为这个细菌 , 也许能打开人类长生的钥匙 。 利用芽孢杆菌F不断自我修复的能力 , 持续地抵抗人体衰老 。 这一发现后 , 布鲁什科夫十分激动 , 他希望自己的发现能改变人类历史 。 于是 , 他开始用动植物做实验 , 植物在注射芽孢杆菌F后长势更快 , 而小白鼠注射后 , 也没有死亡 , 反而变得更活跃 , 而且不容易生病 。
经过一系列实验后 , 他做出一个大胆的决定 , 用自己的身体做实验 。 直接将细菌注射到自己身上 , 看看自己的身体会出现什么反应 。 都说俄罗斯是战斗民族 , 原来俄罗斯的科学家们也如此胆子大 。
350万年前的细菌 , 注射到身体内 , 有太多种可能 , 也许会变异 , 让身体长出不该有的东西 , 也许跟身体无法适应 , 导致生病 。 布鲁什科夫敢于做出这一决定 , 是把自己的生命奉献给科学事业 。
幸运的是 , 在注射后 , 他的身体没有出现排异 , 细菌的状态也很稳定 , 没有发生变异 。 人之所以会死是因为器官和细胞都会衰竭 , 如果人的细胞能和芽孢杆菌F结合 , 也许可以不断自我修复 , 从而达到抗衰的功效 。 在注射后 , 布鲁什科夫公开表达了身体情况 , 他说自己感觉良好 , 身体状况也变好了 , 几年都没有生病 , 并且精神上十分充沛 。
再过了更长时间后 , 布鲁什科夫又对身体进行了检测 , 却发现自己身体里早就没有了那种细菌 。 科学家们认为 , 芽孢杆菌F也许只是一种类似于肠道的有益细菌 。 虽不会对人体造成什么危害 , 但也不会让人变得更加强壮 , 更不会达到长生不老的境界 。
三、全世界面临的衰老问题
现有的生物科学研究指出 , 人体由细胞组成 , 而细胞是在不断衰老的 。
细胞通过分裂来维持生命 , 但细胞每一次分裂后 , 染色体的“端粒”都会减少一部分 , 当这个端粒彻底消失后 , 细胞也就无法分裂 , 也就是说 , 细胞也是消耗型的 。
人体是十分复杂的综合体 , 现在的科学还在持续地研究它 , 除了端粒外 , 肯定还有很多别的影响生命的内在因素 。 如果想要实现长生不老 , 至少要解决这些造成细胞衰老减弱的因素 , 才有可能实现 。
推荐阅读
- 揭秘陶乐德事件:男子在拘留室离奇消失,难道平行时空真的存在?
- 青藏高原将停止增高,后果不可承受,我们却未感到危机
- 寻求气候变化的确定性:要多少才足够?
- 少见!今年十五的月亮,不是十六圆
- 科学家在大型强子对撞机上寻找难以捉摸的基本粒子
- 地球果真出了大问题?火山爆发后出现神秘现象,科学家紧急发声
- 简述相对论发展史:从伽利略到引力波
- 重磅!英美科学家对奥密克戎病毒11个最新判断!对全球意义重大!
- 15000年前海底金字塔被发现,科学家推测:中华文明前身是MU文明
- 人的气运竟然真的存在?科学家竟然已经证实!
